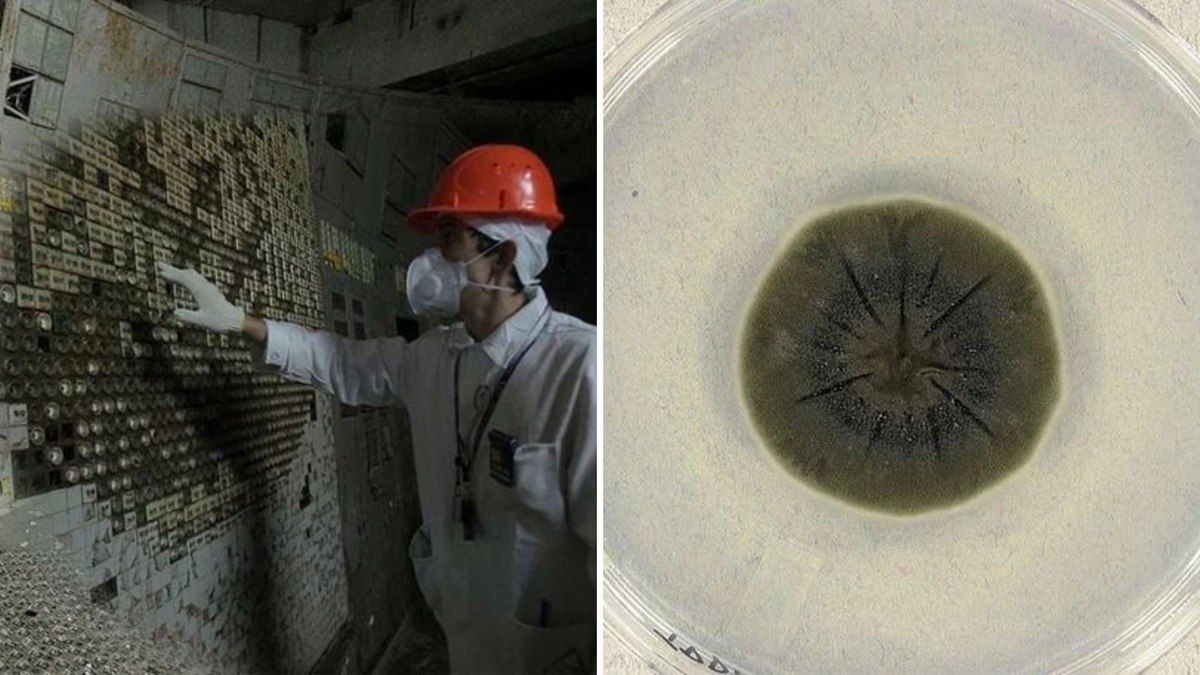
Fungo negro se destaca na radiação de Chernobyl

Fungo negro se destaca na radiação de Chernobyl
01/12/2025, 16:03:25
Introdução ao Fungos em Chernobyl
Mesmo interditada para a presença humana desde a explosão do reator 4, há quase 40 anos, a Zona de Exclusão de Chernobyl tornou-se um inesperado refúgio para diversas formas de vida. Entre elas, um organismo chama atenção da ciência por demonstrar uma capacidade surpreendente: sobreviver e aparentemente prosperar em um dos ambientes mais radioativos do planeta. As informações são do ScienceAlert.
Descoberta do Cladosporium sphaerospermum
A descoberta envolve um fungo de coloração preta que se mantém fixado nas paredes internas de um dos prédios mais contaminados do complexo nuclear. A espécie, chamada Cladosporium sphaerospermum, possui grandes concentrações de melanina, o mesmo pigmento presente na pele humana, e pode estar usando a radiação ionizante como fonte de energia.
Radiossíntese: O Mecanismo Hipotético
Alguns cientistas acreditam que a melanina permita ao fungo captar radiação de forma semelhante ao processo de fotossíntese das plantas, que utilizam a luz solar para gerar energia. Esse mecanismo hipotético recebeu o nome de radiossíntese, embora ainda não tenha sido comprovado de maneira definitiva.
A História da Pesquisa
O mistério começou no fim da década de 1990, quando a microbiologista Nelli Zhdanova, da Academia Nacional de Ciências da Ucrânia, liderou uma expedição à zona de exclusão para identificar quais formas de vida haviam conseguido se estabelecer nas áreas próximas ao reator destruído. O grupo encontrou uma comunidade formada por 37 espécies de fungos, muitas delas com coloração escura ou totalmente negra, característica associada à alta presença de melanina.
Entre todos, o Cladosporium sphaerospermum foi o mais abundante e também o que apresentou os maiores níveis de contaminação radioativa.
Aprofundando os Estudos
Anos depois, uma equipe liderada pela radiofarmacologista Ekaterina Dadachova e pelo imunologista Arturo Casadevall, do Albert Einstein College of Medicine, nos Estados Unidos, aprofundou os estudos sobre o organismo. Os pesquisadores constataram que, diferentemente da maioria dos seres vivos, a exposição à radiação ionizante não apenas não prejudicava o fungo como estimulava seu crescimento.
A radiação ionizante é formada por partículas capazes de remover elétrons dos átomos, causando danos a moléculas e ao DNA, efeitos amplamente conhecidos por prejudicar tecidos humanos e serem usados, por exemplo, em tratamentos contra o câncer. Mesmo assim, o fungo não demonstrava sofrer esses impactos.
Experimentos e Conclusões
Experimentos adicionais indicaram que a melanina do C. sphaerospermum sofre alterações quando submetida à radiação, sugerindo um possível envolvimento do pigmento em um processo de conversão dessa energia em algum tipo de benefício metabólico.
Em um estudo publicado em 2008, Dadachova e Casadevall propuseram oficialmente o conceito de radiossíntese. Segundo a teoria, a melanina exerceria papel parecido ao da clorofila nas plantas, absorvendo radiação e ajudando a transformá-la em energia utilizável pelo organismo, além de servir como um escudo contra os danos mais severos da exposição radioativa.
Fungo no Espaço
Uma pesquisa mais recente, de 2022, levou o fungo para o espaço. Amostras de C. sphaerospermum foram fixadas na parte externa da Estação Espacial Internacional (ISS) para avaliar seu comportamento diante da radiação cósmica. Sensores colocados sob as placas de cultivo mostraram que, onde havia o fungo, menos radiação atravessava o material em comparação com áreas sem o organismo. O objetivo do experimento não era comprovar a radiossíntese, mas investigar o potencial do fungo como material natural de proteção contra radiação em futuras missões espaciais.
Desafios e Futuro das Pesquisas
Apesar dos avanços, a ciência ainda não conseguiu comprovar que o fungo realmente converte radiação em energia. Até agora, os pesquisadores não demonstraram fixação de carbono dependente da radiação, ganho metabólico mensurável ou um caminho bioquímico bem definido que explique a suposta radiossíntese.
Em estudo liderado por Nils Averesch, da Universidade de Stanford, os cientistas afirmaram que "a radiossíntese propriamente dita ainda precisa ser demonstrada", incluindo a transformação de compostos inorgânicos em moléculas energéticas por meio da radiação ionizante.
Comportamentos Universais em Fungos
Outras espécies também apresentam comportamentos incomuns. A levedura negra Wangiella dermatitidis cresce mais sob exposição radioativa, enquanto o fungo Cladosporium cladosporioides aumenta a produção de melanina, mas não se desenvolve mais rápido sob radiação gama ou ultravioleta. Ou seja, esse fenômeno não é uniforme entre fungos pigmentados.
Conclusão: A Resiliência do Cladosporium sphaerospermum
Ainda não se sabe se o comportamento do C. sphaerospermum representa uma verdadeira adaptação para "consumir" radiação ou se é apenas uma resposta de sobrevivência a condições extremas, sem que isso traga, de fato, uma vantagem energética real.
O que está claro é que esse discreto fungo negro encontrou uma forma engenhosa de resistir a um ambiente letal para seres humanos, talvez até crescer em meio ao perigo, reforçando a ideia de que, na Terra, a vida sempre encontra um jeito de seguir em frente, mesmo nos cenários mais improváveis.
